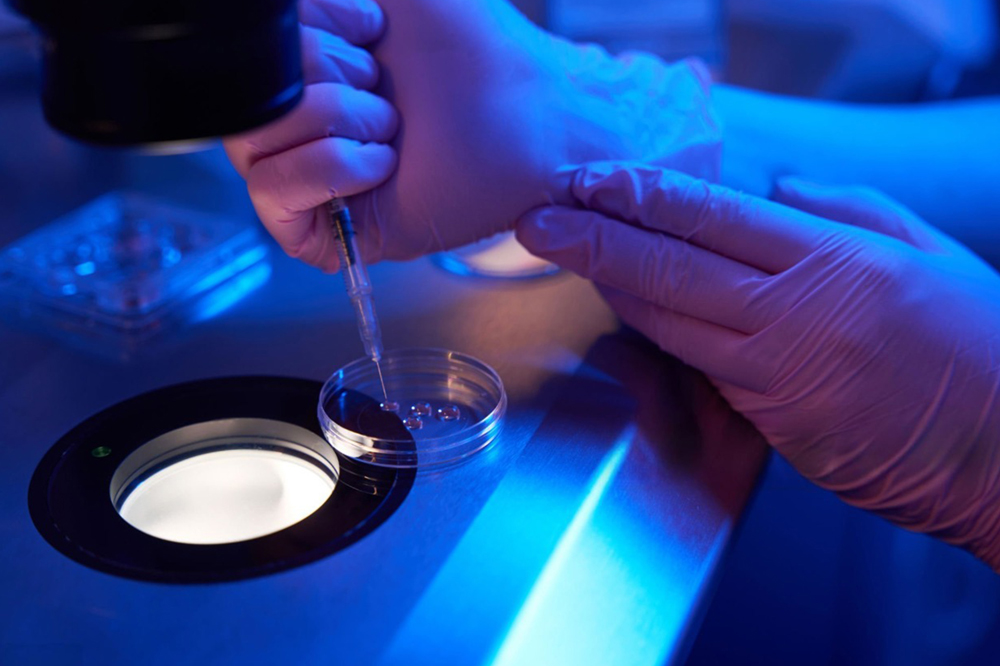
Orthopedic Care

Parenthood is a dream cherished by many couples, but for some, the path to having a baby can be challenging. Infertility affects millions of couples worldwide and can bring emotional, physical, and psychological stress. Fortunately, advances in reproductive medicine have made it possible for many couples to conceive through In Vitro Fertilization (IVF).
IVF has become one of the most effective and widely used fertility treatments, offering hope to couples who struggle with natural conception. For many families, IVF truly becomes a remarkable journey to parenthood.
It can affect both men and women and may occur due to several factors such as hormonal imbalances, reproductive health issues, or lifestyle factors.

Some common causes include:
Male infertility may occur due to:
In many cases, couples may experience unexplained infertility, where no clear cause is identified.
IVF is an advanced fertility treatment where an egg and sperm are fertilized outside the body in a laboratory. Once fertilization occurs, the resulting embryo is carefully transferred into the uterus to achieve pregnancy.
Because fertilization occurs in a controlled environment, IVF significantly increases the chances of conception for couples facing infertility.
Understanding the IVF process can help couples feel more confident and prepared for the treatment journey.
Regular monitoring through blood tests and ultrasound scans ensures proper follicle development.
IVF can be recommended for couples experiencing:
IVF is also helpful for couples who have been trying to conceive for many years without success.